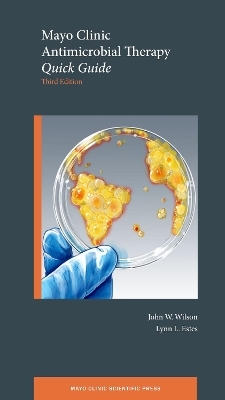
Mayo Clinic Antimicrobial Therapy

Effective Clinical Management in the Age of All-Oral Therapy
Buch | Softcover
2018
|
Oxford University Press Inc
ISBN: 9780190238285
CHF 76,95 (inkl. MwSt)
- Versand in
15-20 Tagen